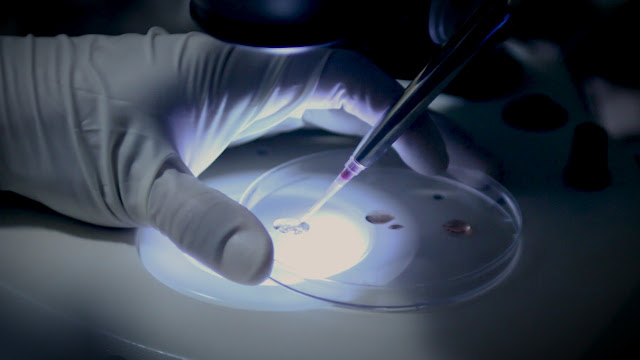

O melhoramento genético elevou o patamar do país no ranking dos produtores e nos tornou o maior exportador de carne bovina do mundo
O patrimônio genético do rebanho está diretamente relacionado com a eficiência do sistema de produção. Porém, os programas de melhoramento podem ser perfeitamente implementados em qualquer propriedade. Paralelo a esse trabalho, as boas práticas de manejo, sanidade e nutrição animal promovem a máxima expressão do potencial genético dos bovinos.
Quando fazer o melhoramento genético no gado de corte?
O objetivo dos programas de melhoramento genético no gado é classificar e ordenar os bovinos com a finalidade de seleção, visando a alcançar o melhor valor econômico da atividade.
Nesse cenário, podemos dizer que esse é um processo contínuo, um investimento de longo prazo.
Como fazer o melhoramento genético no gado de corte?
Seleção — é a escolha dos animais que serão os progenitores da próxima geração.
Sistemas de acasalamento — é a definição de quais touros serão cruzados com quais vacas. Entre eles, o principal é o cruzamento de raças distintas.
O melhor animal: como definir?
O objetivo da seleção é estabelecer o valor genético de uma característica, mensurado pela importância econômica que ela tem. Você pode estipular qual o perfil mais adequado para o seu negócio: com propensão a aumentar o peso ou para reduzir a idade ao primeiro parto, entre outras características.
Critérios de Seleção. Depois de identificar todos os seus animais com uma numeração permanente, é preciso estabelecer quais são as características que serão medidas para, então, classificar os bovinos e, por fim, selecioná-los.
Aqui, é preciso destacar que a relevância de cada atributo depende diretamente do objetivo da seleção adequada à sua produção. Mas é importante atentar para a fertilidade, as habilidades maternais e para as características que demonstrem o dimorfismo sexual, ou seja, as de masculinidade e de feminilidade.
Ademais, as características devem estar muito bem avaliadas para que, durante o procedimento estatístico, se consiga separar os efeitos genéticos aditivos nos animais.
Separe os grupos de contemporâneos. Separe os grupos de animais que nasceram na mesma época e que tenham recebido exatamente os mesmos manejos nutricionais e sanitários. Somente assim é possível identificar e comparar facilmente as características. Os animais que estão em seleção são expostos aos mesmos tratamentos e condições ambientais, para que os fatores externos não interfiram no desempenho dos bovinos e as características genéticas sejam evidenciadas. Essa padronização aumenta a precisão no processo de seleção.
Faça a Avaliação Genética. Este processo prediz o valor genético dos animais para as características economicamente importantes. Então, os dados zootécnicos obtidos no campo são analisados por cálculos de estatística adequados, para que os animais sejam corretamente classificados. Atenção: a confiabilidade da avaliação genética depende da qualidade dos dados coletados.
Proceda à Seleção. Separe os animais em quatro categorias: machos jovens, machos antigos, fêmeas jovens e fêmeas antigas. Depois, os integrantes de cada grupo serão classificados e os que se saírem melhor serão selecionados, de acordo com a característica-alvo da seleção.
É importante não usar touros por muito tempo na reprodução, pois isso atrasa o processo de melhoramento genético ao reduzir a taxa de natalidade do rebanho, uma vez que à medida que ele envelhece, sua fertilidade diminui. Da mesma forma, descarte as vacas e as novilhas vazias. Procure sempre utilizar touros e vacas jovens, substituindo os mais antigos por animais melhorados.
Proceda aos Acasalamentos. Após ter selecionado os melhores animais do seu rebanho, é hora de estabelecer a estação de monta. Aqui, é fundamental evitar os acasalamentos endogâmicos, isto é, entre indivíduos aparentados. Montar a árvore genealógica do seu touro evita a consanguinidade, impedindo que o touro acasale com suas filhas.
É muito importante manter a variabilidade genética no rebanho, pois a falta dela conduz a enfermidades e problemas congênitos. É possível fazer isso incorporando animais de linhagens diferentes nos cruzamentos. Essa é, aliás, uma das vantagens da inseminação artificial em bovinos. Outros métodos igualmente satisfatórios são a fertilização in vitro (FIV) e a transferência de embriões.
É imprescindível que você avalie periodicamente o programa implementado na sua fazenda para averiguar se os processos estão trazendo bons resultados.
Lembramos que os efeitos e os ganhos obtidos por meio das técnicas de seleção são cumulativos, ou seja, mantêm-se presentes no rebanho mesmo que o programa seja interrompido por um tempo. Portanto, vale o investimento nessa tecnologia.
O melhoramento genético em gado de corte é uma das premissas para garantir a sustentabilidade da pecuária no país. Além disso, é o fator responsável por ter transformado o Brasil de importador de bovinos a exportador de patrimônio genético superior e, também, pelos pecuaristas terem deixado de ser apenas colecionadores de animais para se tornarem selecionadores.
Leia também: